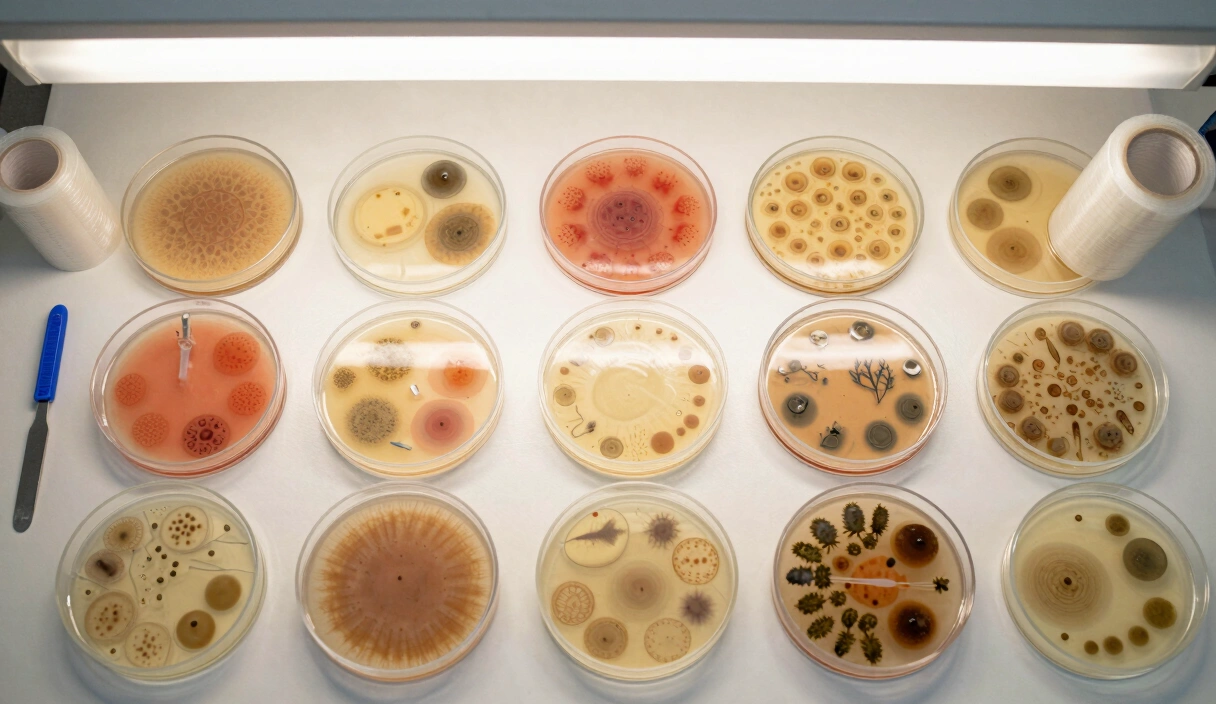
Agar and Genetics

Mushroom Breeding: The Science of Strain Crossing and Hybrid Vigor
Crossing mushroom strains for better yields. Monokaryotic isolation, clamp connection verification, and what hybrid vigor actually means for growers.

Crossing mushroom strains for better yields. Monokaryotic isolation, clamp connection verification, and what hybrid vigor actually means for growers.

The right way to take spore prints, make syringes, and store genetics for years. Covers foil vs. glass, hydration, and long-term viability.

How to make, store, and expand mushroom liquid cultures. Covers peptone ratios, sugar clarity, and why a $22 stir plate beats a $60 one.

How to isolate fast-growing mushroom genetics on agar through sectoring. Includes transfer protocols and signs of mycelial senescence.

MEA, PDA, and antibiotic agar — five tested recipes with exact measurements for isolating clean mushroom cultures on plates.

Master the "black belt" of mycology. From Fanny Hesse’s kitchen discovery to advanced genetic sectoring, we explore the physics, chemistry, and real-world hacks of agar work.